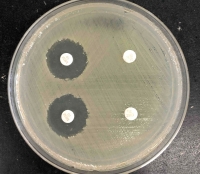
薬剤感受性試験

本文
福岡県のワンヘルスに関する主な取り組み
福岡県では、福岡県ワンヘルス推進行動計画に基づき、さまざまな取組を行っています。
【 目次 】
1.愛玩動物の病原体保有状況調査
2.野生動物の病原体保有状況調査
3.薬剤耐性菌調査
4.里地里山における野生動物の生息状況調査
5.大気・水・土壌環境保全対策
6.犬猫の引取り数抑制・譲渡促進事業
7.野生動物との棲み分けを図る里山林の整備
8.ワンヘルスの森づくり
9.アニマルセラピーによる健康づくり
10.農林漁業の応援団づくりにより地産地消を推進
11.ワンヘルス教育の推進
12.アジア新興・人獣共通感染症センター(仮称)の誘致
13.ワンヘルスフェスタ
14.福岡県ワンヘルスマスター
15.ワンヘルス国際フォーラム
16.ワンヘルスセンター
17.ワンヘルスカードゲーム
1.愛玩動物の病原体保有状況調査(共通感染症発生状況等調査)
2014(平成26)年度から県内動物病院の協力のもと、もっとも身近な愛玩動物(ペット)である犬や猫を対象に、人獣共通感染症を引き起こす病原体の保有状況調査(人獣共通感染症発生状況等調査)を行っています。得られた結果は、医療や獣医療、行政関係者で共有し、人に感染した場合の迅速な診断につなげるなど、人獣共通感染症対策に役立てています。


犬から採材の様子 PCR検査の様子と検査結果
2.野生動物の病原体保有状況調査
西日本を中心に、人獣共通感染症の「重症熱性血小板減少症候群(SFTS)」の感染者報告数が年々増加傾向にあり、福岡県においても、死亡例が確認されています。このため、感染拡大の要因の一つとして考えられる野生動物(シカ、イノシシ、アライグマ)を対象に、SFTSウイルスの感染状況を調査します。この調査結果に基づき、市町村、医療機関、県民などに対して情報提供
〔自然環境課〕



シカ イノシシ アライグマ
3.薬剤耐性菌調査
県民、医療・獣医療関係者などに抗微生物剤の適正使用を推進するため、愛玩動物における薬剤耐性菌の発生動向調査、河川水の薬剤耐性菌や抗微生物剤の実態調査を行っています。
・愛玩動物における薬剤耐性菌の発生動向調査
愛玩動物を対象にした薬剤耐性菌調査については、2017(平成29)年度から国主導により実施されていますが、全国的な状況把握を目的としているため、福岡県の状況は十分に把握されていません。
薬剤耐性菌について、動物から人、人から動物への伝播が懸念されています。特に人との濃厚な接触機会が多い愛玩動物の調査・監視が必要と考えられるため、福岡県独自で愛玩動物の薬剤耐性菌を調査し、その状況を把握する必要があります。
〔ワンヘルス総合推進課〕

薬剤感受性検査 薬剤感受性試験の様子
・河川水における薬剤耐性菌及び抗微生物剤の実態調査
抗微生物剤の環境汚染による薬剤耐性の拡がりと人へのリスクが懸念されていますが、環境中の薬剤耐性や抗微生物剤については、事業所等からの排出基準がなく、また調査法の確立等の遅れから、全国的な調査が進んでいない状況です。
このため、環境中の薬剤耐性菌対策には、人や動物に使用される抗微生物剤や発生した薬剤耐性菌が、河川等の環境水の中にどの程度流出し、人の日常生活にどのように循環し、リスクへと発展するのかを評価することが必要です。この調査では、自然環境に対する影響を明らかにできる河川水について、薬剤耐性菌等を対象とした福岡県独自の調査体制を整え、環境中の薬剤耐性による農産物や野生動物等の自然環境への影響を把握します。
〔ワンヘルス総合推進課〕

次世代シークエンサーによる解析 河川水の採水
4.里地里山における野生動物の生息状況調査
人と自然が共生し、多くの絶滅危惧種が生息・生育する里地里山では、農林業の変化や農山村の過疎化にともない、自然に対する人の働きかけが縮小することで、生態系のバランスが崩れ、生物多様性の損失が懸念されています。また、里地里山の手入れが行き届かなくなることで、シカやイノシシ等の生息域が拡大しています。生物多様性保全の観点から、里地里山ではどのような野生動物が生息しているか、また野生動物と植物や昆虫等との関わりを明らかにする必要があります。
そこで、痕跡調査に加え、センサーカメラを設置し、その地域に生息する野生動物の種類やその行動を把握するほか、野生動物が入らない柵を設け、柵内外での被食植物や植生、昆虫類の変化を把握します。
本調査や各地の取組事例をふまえ、里地里山における生物多様性の保全・再生策の方向性をまとめ、地域住民や事業者など、さまざまな立場の方々による保全・再生活動が促進されるよう、ホームページで情報発信します。
〔自然環境課〕

センターカメラによる野生動物調査
5.大気・水・土壌環境保全対策
・大気・水環境の常時監視
健康で快適に暮らせる生活環境を確保するため、大気環境について、県内55の常時監視測定局で大気汚染物質の測定を行うとともに、工場・事業場の監視指導を行っています。また、微小粒子状物質(PM2.5)や光化学オキシダントが高濃度になった場合には注意報などを発令し、県民に注意を呼びかけています。
また、水環境について、県内185の環境基準点で水質測定を行うとともに、油流出などの水質事故時には、関係機関との情報共有や水質検査を実施し、被害拡大を防止しています。
〔環境保全課〕

水質検査の様子
・石綿飛散防止
石綿(アスベスト)は、肺がんや中皮腫を発症する発がん性が問題となり、現在は製造・使用等が禁止されていますが、製造・使用等の禁止前に建設された建築物(石綿含有建材が使用された建築物等)が順次耐用年数を迎えるため、今後、解体等工事の増加が見込まれています。このため、デジタル技術(VR)を活用した講習会の開催により、石綿含有建材の調査能力などの向上を図るとともに、解体等工事現場への立入検査等により、石綿の飛散防止に取り組んでいます。
〔環境保全課〕
VR講習会の様子
6.犬猫の引取り数抑制・譲渡促進事業
致死処分数をさらに削減するには、地域猫活動支援事業(※)による引取り数の減少、犬猫譲渡事業による新たな飼い主への譲渡促進が必要です。
地域猫活動支援事業を進めていくため、活動のポイントや成功事例を紹介する動画を市町村に配布するとともに、不妊去勢手術費などの補助金の拡充を行います。また、犬猫の譲渡事業促進のため、譲渡割合が増加している動物愛護団体に対して、飼養管理費や不妊去勢手術費等の譲渡活動に係る経費について、支援を行います。
引取り数の削減及び譲渡の促進により、致死処分数をさらに削減できるよう、人と動物が共生できる社会づくりを推進します。
※地域猫活動支援事業
飼い主のいない猫に対する不妊去勢手術費等の市町村への助成
〔生活衛生課〕

(上)譲渡事業を行う(公財)福岡県動物愛護センターの
新設猫舎(イメージ図)
(下)譲渡を待つ猫
7.野生動物との棲み分けを図る里山林の整備
近年、里山林に人の手が入らない地域では、人と野生動物の距離が近くなり、野生動物による農林業被害が発生しています。このため、野生動物の生息域を確保するとともに、人と野生動物との棲み分けを進めることで、人と野生動物の共存を図ります。
具体的には、野生動物の生息地となる広葉樹林を確保するため、広葉樹を植栽し、また、野生動物による農作物などへの被害が生じている地域の里山林においては、不要な雑木の除去などを行い、野生動物が身を隠すことができない見通しの良い森林区域であるバッファーゾーン(緩衝地帯)を設置します。
〔林業振興課〕

生息地となる広葉樹林 バッファーゾーンのイメージ
8.ワンヘルスの森づくり
大野城市、太宰府市、宇美町にまたがる約340haの森林公園「四王寺県民の森」を「ワンヘルスの森」として位置づけ、ワンヘルスに対する理解の促進と、心身の健康づくりを進めています。この「ワンヘルスの森」では、人と動物と森林の関わりなどについて、パネルなどの分かりやすい展示物や案内板で解説します。
また、県民向けの「ワンヘルス体験ツアー」でワンヘルスを実感できる森林浴などを実施すると同時に、こうした取組をホームページやSNSなどで広く周知し、健康づくりの推進やワンヘルス教育の場としての活用につなげます。
〔林業振興課〕

四王寺県民の森全景 ワンヘルス体験ツアーのイメージ
9.アニマルセラピーによる健康づくり
障がい児の社会生活適応力の向上を目指し、2016(平成28)年度から障がい児の乗馬体験等を行うホースセラピー事業を行っています。臨床心理士によるアンケート等を用いた効果検証では、参加児童が馬とのふれあいを楽しむ中で、馬への愛着を深めるとともに、自分自身をコントロールする感覚を取り戻すなど、好ましい心理的効果が確認されています。
今後、新たに障がい児施設等にセラピー犬を派遣してセラピー活動を行うなど、障がい児等の身体的・精神的な健康を促し、アニマルセラピーの普及啓発を図ります。
〔障がい福祉課〕

ホースセラピーの様子 乗馬のあとは馬の世話も体験
10.農林漁業の応援団づくりにより地産地消を推進
福岡県では、県内の豊かな食材を県民みんなでおいしくいただき、食と食を支える農林水産業の重要性について理解を深めてもらうため、「いただきます!福岡のおいしい幸せ」のスローガンのもと、「食育・地産地消県民運動」を展開しています。今後も「ふくおか農林漁業応援団」の輪を広げ、一人一人が農林水産業を身近に感じてもらえるよう、地産地消を推進します。
・ふくおか農林漁業応援団
「地産地消応援ファミリー」:県産農林水産物を積極的に購入し、農林水産業を応援する世帯
「地産地消応援の店」:県産農林水産物を使用した料理を年間通じて提供する飲食店
「農林漁業応援団体」:県産農林水産物の利用拡大や農山漁村の活性化に貢献する企業や団体
〔食の安全・地産地消課〕

11.ワンヘルス教育の推進
小中高生向けに、ワンヘルスを知るきっかけづくりを目的とした教育啓発資料(リーフレット)を作成し、県内全ての小学校4年生、中学校1年生、高校の全生徒と全教職員に配布しています。
また現在、県立高校8校と私立高校2校、計10校において、理科や地理・歴史・公民、保健体育科などの教科に加え、工業や農業などの専門科目によるワンヘルス教育の実践を行っています。これまで学校教育では、さまざまな教科などを通じて、人の健康に関することや環境問題に触れることはありましたが、「ワンヘルス」という考え方をとりあげ、教育を行うことは全国初の取組です。
〔教育庁〕



ワンヘルス教育啓発資料 ワンヘルス教育教材 子供のためのワンヘルスリーフレット
12.アジア新興・人獣共通感染症センター(仮称)の誘致
九州は、地理的にアジア諸国由来の人獣共通感染症、気候変動による蚊やダニ等の媒介動物由来の感染症が流行するリスクが高い地域です。
また、国際的な課題となっている薬剤耐性対策については、アジア各国から我が国の知識・人材・技術が求められています。
これに対応するためには、アジア諸国由来の人獣共通感染症や薬剤耐性についてワンヘルス・アプローチによる対策を行う拠点が必要になります。
そこで福岡県では、アジア各国、九州各県、大学等が連携して、人獣共通感染症や薬剤耐性対策を行う「アジア新興・人獣共通感染症センター(仮称)」を九州に早期設置するよう国へ働きかけています。
〔ワンヘルス総合推進課〕
13.ワンヘルスフェスタ
県民の皆様にワンヘルスに対する理解を深めてもらうことを目的に、2020(令和2)年度から毎年開催しています。
2021(令和3)年度は、筑後市の九州芸文館で、トークショーやパネル展をはじめ、セラピードッグとのお散歩体験、地産地消メニューの販売など、ワンヘルスを身近に感じられるイベントを実施しました。
また、地元の高校生の皆さんにもご協力いただき、八女茶の販売や乗馬体験も行いました。
今後も様々なコーナーを企画していきますので、是非ご参加ください。
〔ワンヘルス総合推進課〕


クイズ大会 ふれあい動物園
14.福岡県ワンヘルスマスター
福岡県では、ワンヘルスの基本(理念、歴史、現状)から実践的なワンヘルスの取組例まで教えることができ、積極的にワンヘルスの啓発活動を行う「福岡県ワンヘルスマスター」を育成するため、「ワンヘルスマスター育成プログラム」を実施しています。
育成プログラムでは、福岡県ワンヘルス推進行動計画の7つ柱に沿った講座(座学・体験学習)を学び、修了した方をワンヘルスマスターとして認定しています。
また、認定されたワンヘルスマスターを地域や職場、学校等で学習会等を開催される方に対し、講師として紹介する事業を実施しています。
※詳しくは「福岡県ワンヘルスマスター紹介事業」
〔ワンヘルス総合推進課〕
15.福岡県ワンヘルス国際フォーラム
新型コロナウイルス感染症をはじめとする人獣共通感染症などに対して、医療、獣医療、環境など各分野の世界トップクラスの研究者がワンヘルスアプローチにより解決することを目指し、研究成果などを世界に向けて発信するため、令和2年度から毎年開催しています。
※詳しくは「福岡県ワンヘルス国際フォーラム」
〔ワンヘルス総合推進課〕


「福岡県ワンヘルス国際フォーラム」の様子
16.ワンヘルスセンター
新興感染症や地球温暖化などのワンヘルスの課題に対応する実践拠点として、全国初の「ワンヘルスセンター」を整備します。
その中核施設として、人の健康や環境保全に関する調査・研究を行う「保健環境研究所」を移転・建設するとともに、家畜、愛玩動物、動物園などで飼育されている展示動物、野生動物の保健衛生を一元的に担う「動物保健衛生所」を新設します。他に類を見ない、「人」、「動物」、「環境」の各分野に関する一体的な調査・研究ができる特徴を生かして、ワンヘルスに関する先進的な調査・研究や専門人材の育成などを進めていきます。
ワンヘルスセンターは、みやま市の保健医療経営大学跡地に整備し、2027(令和9)年度中の供用開始を目指しています。
※詳しくは「ワンヘルスセンター」
〔ワンヘルス総合推進課・自然環境課・畜産課・保健環境研究所〕


17.ワンヘルスカードゲーム
福岡県では、県民の皆様にワンヘルスを実践してもらうために、自らの行動がどのような影響を社会に与えるか疑似的に体験し、ワンヘルスを学ぶことができるカードゲームを制作しました。カードゲームを体験した方が「自らの行動が社会を変えていける」という実感を得られるゲームとなっています。
所要時間:約90分
参加人数:6人から48人(1セットあたり)
対象年齢:子どもから大人まで(小学5年生以上推奨)
※詳しくは「ワンヘルスカードゲーム」
〔ワンヘルス総合推進課〕


カードゲーム体験の様子 ワンヘルスカードゲーム









